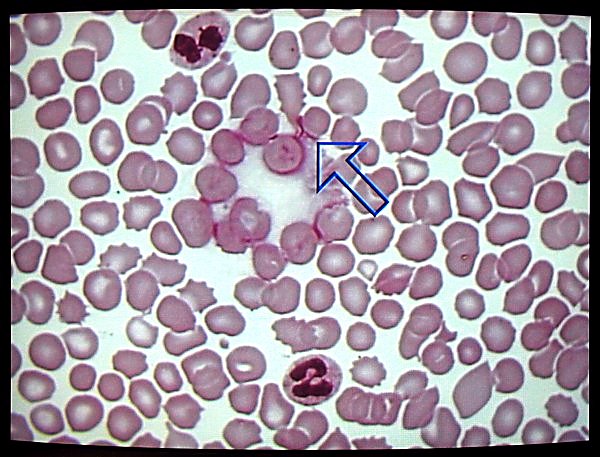

Description
The latest VP series of video pointing devices from MicroImage Video Systems, the VP300, improves on virtually every aspect of our previous models, while retaining their legendary ease of use. The new units incorporate substantial digital processing and timing for solid performance. As always, the new pointers will work with most common NTSC and PAL video formats including S-Video, composite video and black & white video. RGB (with or without external sync) is available as a custom order item.
The MicroImage Video Systems? VP300 is the latest generation of video pointers. Included are many enhancements while at the same time reducing the size and cost compared to the previous generation units. The VP300 supports S-Video, composite and black & white video sources.
Video pointers are commonly used in presentations, classrooms, video instruction, surgery and forensic documentation to highlight a specific item on the display. They are especially useful when an image is displayed on more than one monitor, since the pointer can be active on all monitors at the same time. Video pointers are also used in applications where the personnel must be kept at a distance, such as surgery or remote testing. As opposed to traditional methods of pointing (finger, laser/stick pointers or grease pencil), the electronic image of the video pointer is easily recorded on video tape or printed with a video printer.
The video pointer allows the user to place an arrow, box, circle or cross hair symbol on the video display and move it to virtually any position with a joystick control. Each shape is available in several sizes for maximum flexibility. Arrows may also be rotated to one of eight directions. There are dedicated switches to select shape, size and rotation.
The symbol display may have an optional border enabled, which will make it appear more prominent on the display. The symbol color and the border color may each be set independently to one of eight colors or transparent. There is a switch to set the color and another to set the border color. Symbols will be displayed in color when using NTSC composite video, S-Video and RGB. When using a black & white video source, they are shown as shades of gray. PAL composite and S-video systems will only generate shades of gray, while PAL RGB will generate all colors.
The symbol may be turned on or off at any time, simply by pressing the display switch on the front panel. Turning off the display switch allows the video signal to pass through, but the symbol will not be displayed on the screen. The symbols can also be made to flash by pressing the “flash” switch, thereby drawing attention to the selected portion of the image.
A color bar test signal generator is built into the VP300. This makes it easy to color match and test multiple monitors in a classroom or similar application. Grayscale bars are produced for all monochrome systems and for PAL composite and PAL S-Video.
The VP300 will operate from a +12VDC (+10 to 20VDC) power source. A wall unit power supply is included with each unit. Please contact MicroImage Video Systems for units that operate with RGB video signals.
Rack mount and RoHS units are not available for this product.
The VP300 is available packaged (cased) or as a board level product for OEM applications. Power is provided by a universal
?desktop power supply (included with cased products) or it can be operated from +12VDC (negative ground). Board level products do not include the power supply and a 12VDC power source must be provided.? The cased unit is packaged in a durable metal enclosure. Board Level, OEM and Custom products are also available. Please contact MicroImage Engineering for additional information.
The VP300 has a one year parts and labor limited warranty.
|
Key Specifications |
|||||||||||||||||||||||||||||||||||||||||||||||||||||||||||||||||||||||||||||||||||||||||||||||||||||
|
|||||||||||||||||||||||||||||||||||||||||||||||||||||||||||||||||||||||||||||||||||||||||||||||||||||